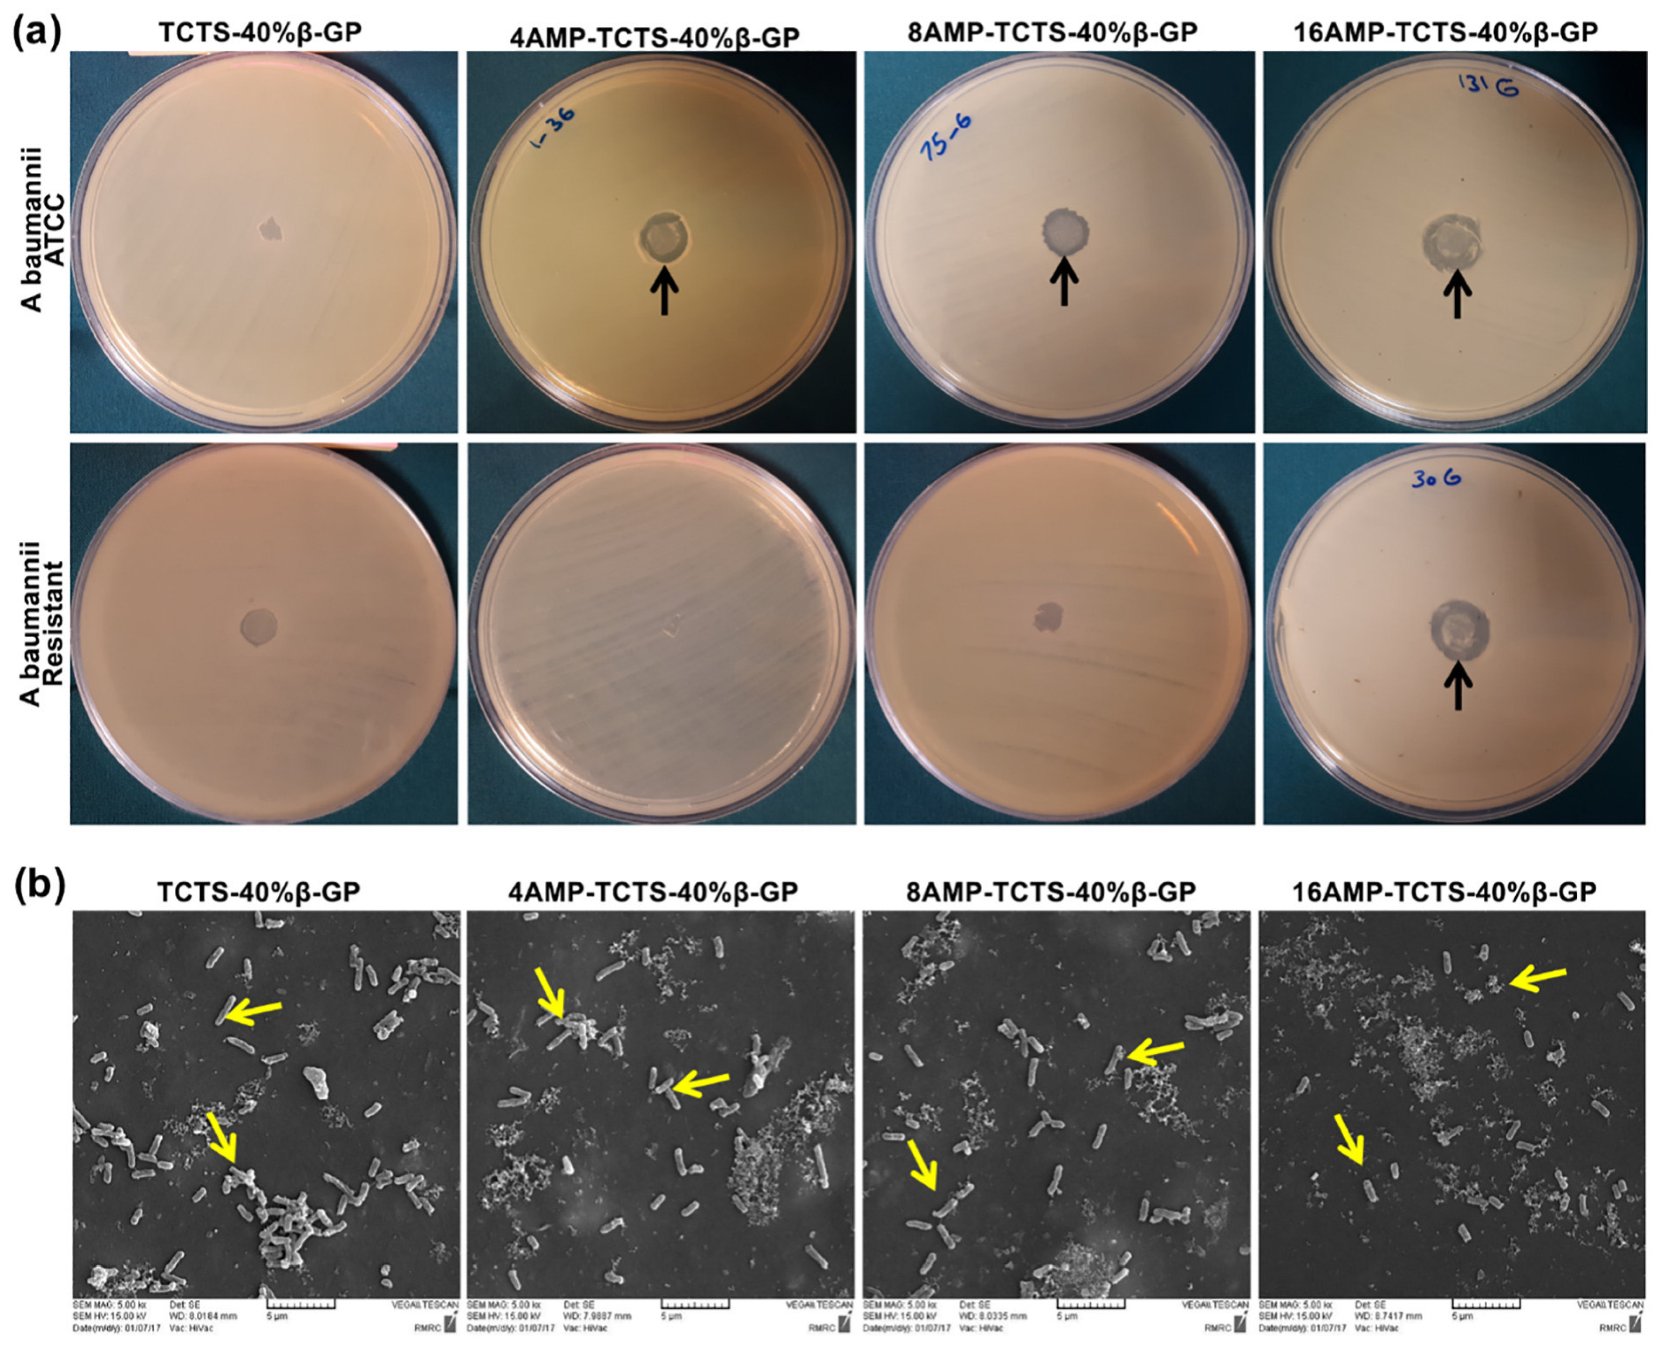
Gels 09 00802 g004

Stimuli-Responsive Hydrogels for Protein Delivery
Abstract
:1. Introduction
2. Therapeutic Proteins
2.1. Characteristics
2.2. Delivery of Therapeutic Proteins
2.2.1. Parenteral Route
2.2.2. Oral Route
2.2.3. Nasal Route
2.2.4. Pulmonary Route
2.2.5. Ocular Route
2.2.6. Transdermal Route
3. Hydrogels
3.1. Definition
3.2. Stimuli-Responsive Polymers
3.2.1. Temperature-Responsive Polymers
3.2.2. pH-Responsive Polymers
3.2.3. Ionic Strength-Responsive Polymers
3.2.4. Biomolecule-Responsive Polymers
3.2.5. Enzyme-Responsive Polymers
3.2.6. Dual and Multiple Stimuli-Responsive Polymers
4. Stimuli-Responsive Hydrogels for Protein Delivery
5. Conclusions and Future Perspectives
Author Contributions
Funding
Conflicts of Interest
References
- Bajracharya, R.; Song, J.G.; Back, S.Y.; Han, H.K. Recent Advancements in Non-Invasive Formulations for Protein Drug Delivery. Comput. Struct. Biotechnol. J. 2019, 17, 1290–1308. [Google Scholar] [CrossRef] [PubMed]
- Walsh, G. Biopharmaceutical benchmarks 2018. Nat. Biotechnol. 2018, 36, 1136–1145. [Google Scholar] [CrossRef]
- Asfour, M.H. Advanced trends in protein and peptide drug delivery: A special emphasis on aquasomes and microneedles techniques. Drug Deliv. Transl. Res. 2021, 11, 1–23. [Google Scholar] [CrossRef] [PubMed]
- Florence, A.T.; Attwood, D. Physicochemical Principles of Pharmacy: In Manufacture, Formulation and Clinical Use, 6th ed.; Pharmaceutical Press: London, UK, 2015. [Google Scholar]
- Lin, J.H. Pharmacokinetics of biotech drugs: Peptides, proteins and monoclonal antibodies. Curr. Drug Metab. 2009, 10, 661–691. [Google Scholar] [CrossRef] [PubMed]
- Irianti, M.K.; Rahmasari, R.; Arifianti, A.E.; Iswandana, R. Non-invasive strategies for protein drug delivery: Oral, transdermal, and pulmonary. J. Appl. Pharm. Sci. 2020, 10, 166–179. [Google Scholar] [CrossRef]
- Vermonden, T.; Censi, R.; Hennink, W.E. Hydrogels for protein delivery. Chem. Rev. 2012, 112, 2853–2888. [Google Scholar] [CrossRef]
- Bae, K.H.; Kurisawa, M. Emerging hydrogel designs for controlled protein delivery. Biomater. Sci. 2016, 4, 1184–1192. [Google Scholar] [CrossRef]
- Narayanaswamy, R.; Torchilin, V.P. Hydrogels and Their Applications in Targeted Drug Delivery. Molecules 2019, 24, 603. [Google Scholar] [CrossRef]
- Chatterjee, S.; Hui, P.C.-l. Stimuli-Responsive Hydrogels: An Interdisciplinary Overview. In Hydrogels; Lăcrămioara, P., Mihaela Violeta, G., Cristina-Elena, D.-P., Eds.; IntechOpen: Rijeka, Croatia, 2018; Chapter 2. [Google Scholar]
- Vasudevan, D.; Sreekumari, S.; Vaidyanathan, K. Proteins: Structure and Function. In Textbook of Biochemistry for Medical Students; Jaypee Brothers Medical Publishers: New Delhi, India, 2017; pp. 36–51. [Google Scholar]
- Jain, A.; Jain, A.; Gulbake, A.; Shilpi, S.; Hurkat, P.; Jain, S.K. Peptide and protein delivery using new drug delivery systems. Crit. Rev. Ther. Drug Carrier Syst. 2013, 30, 293–329. [Google Scholar] [CrossRef]
- Deb, P.K.; Al-Attraqchi, O.; Chandrasekaran, B.; Paradkar, A.; Tekade, R.K. Protein/Peptide Drug Delivery Systems: Practical Considerations in Pharmaceutical Product Development. In Basic Fundamentals of Drug Delivery; Tekade, R.K., Ed.; Academic Press: Cambridge, MA, USA, 2019; pp. 651–684. [Google Scholar]
- de la Torre, B.G.; Albericio, F. The Pharmaceutical Industry in 2019. An Analysis of FDA Drug Approvals from the Perspective of Molecules. Molecules 2020, 25, 745. [Google Scholar] [CrossRef]
- Mullard, A. 2019 FDA drug approvals. Nat. Rev. Drug Discov. 2020, 19, 79–84. [Google Scholar] [CrossRef]
- Mullard, A. 2020 FDA drug approvals. Nat. Rev. Drug Discov. 2021, 20, 85–90. [Google Scholar] [CrossRef] [PubMed]
- Martins, A.C.; Albericio, F.; de la Torre, B.G. FDA Approvals of Biologics in 2022. Biomedicines 2023, 11, 1434. [Google Scholar] [CrossRef] [PubMed]
- Carter, P.J. Introduction to current and future protein therapeutics: A protein engineering perspective. Exp. Cell Res. 2011, 317, 1261–1269. [Google Scholar] [CrossRef] [PubMed]
- de la Torre, B.G.; Albericio, F. The Pharmaceutical Industry in 2021. An Analysis of FDA Drug Approvals from the Perspective of Molecules. Molecules 2022, 27, 1075. [Google Scholar] [CrossRef] [PubMed]
- Leader, B.; Baca, Q.J.; Golan, D.E. Protein therapeutics: A summary and pharmacological classification. Nat. Rev. Drug Discov. 2008, 7, 21–39. [Google Scholar] [CrossRef] [PubMed]
- Timofeev, V.; Samygina, V. Protein Crystallography: Achievements and Challenges. Crystals 2023, 13, 71. [Google Scholar] [CrossRef]
- Voet, D.; Voet, J.G. Amino acids. In Biochemistry, 4th ed.; John Wiley & Sons: New York, NY, USA, 2010; pp. 67–78. [Google Scholar]
- Liang, W.; Pan, H.W.; Vllasaliu, D.; Lam, J.K.W. Pulmonary Delivery of Biological Drugs. Pharmaceutics 2020, 12, 1025. [Google Scholar] [CrossRef]
- Awwad, S.; Angkawinitwong, U. Overview of antibody drug delivery. Pharmaceutics 2018, 10, 83. [Google Scholar] [CrossRef]
- Datta-Mannan, A. Mechanisms Influencing the Pharmacokinetics and Disposition of Monoclonal Antibodies and Peptides. Drug Metab. Dispos. 2019, 47, 1100–1110. [Google Scholar] [CrossRef]
- Joseph, M.; Trinh, H.M.; Mitra, A.K. Peptide and Protein-Based Therapeutic Agents. In Emerging Nanotechnologies for Diagnostics, Drug Delivery and Medical Devices; Mitra, A.K., Cholkar, K., Mandal, A., Eds.; Elsevier: Boston, MA, USA, 2017; pp. 145–167. [Google Scholar]
- Goldberg, M.; Gomez-Orellana, I. Challenges for the oral delivery of macromolecules. Nat. Rev. Drug Discov. 2003, 2, 289–295. [Google Scholar] [CrossRef] [PubMed]
- Tiam, F.; Adam, H.; Remigius, U.A. Noninvasive Strategies for Systemic Delivery of Therapeutic Proteins—Prospects and Challenges. In Smart Drug Delivery System; Ali Demir, S., Ed.; IntechOpen: Rijeka, Croatia, 2016; Chapter 8. [Google Scholar]
- Renukuntla, J.; Vadlapudi, A.D.; Patel, A.; Boddu, S.H.; Mitra, A.K. Approaches for enhancing oral bioavailability of peptides and proteins. Int. J. Pharm. 2013, 447, 75–93. [Google Scholar] [CrossRef]
- Vugmeyster, Y.; Xu, X.; Theil, F.P.; Khawli, L.A.; Leach, M.W. Pharmacokinetics and toxicology of therapeutic proteins: Advances and challenges. World J. Biol. Chem. 2012, 3, 73–92. [Google Scholar] [CrossRef] [PubMed]
- Jain, D.; Mahammad, S.S.; Singh, P.P.; Kodipyaka, R. A review on parenteral delivery of peptides and proteins. Drug Dev. Ind. Pharm. 2019, 45, 1403–1420. [Google Scholar] [CrossRef] [PubMed]
- Ibeanu, N.; Egbu, R.; Onyekuru, L.; Javaheri, H.; Khaw, P.T.; Williams, G.R.; Brocchini, S.; Awwad, S. Injectables and Depots to Prolong Drug Action of Proteins and Peptides. Pharmaceutics 2020, 12, 999. [Google Scholar] [CrossRef]
- Usach, I.; Martinez, R.; Festini, T.; Peris, J.E. Subcutaneous Injection of Drugs: Literature Review of Factors Influencing Pain Sensation at the Injection Site. Adv. Ther. 2019, 36, 2986–2996. [Google Scholar] [CrossRef]
- Mueller, C.; Altenburger, U.; Mohl, S. Challenges for the pharmaceutical technical development of protein coformulations. J. Pharm. Pharmacol. 2018, 70, 666–674. [Google Scholar] [CrossRef]
- Jackisch, C.; Müller, V.; Maintz, C.; Hell, S.; Ataseven, B. Subcutaneous Administration of Monoclonal Antibodies in Oncology. Geburtshilfe Frauenheilkd 2014, 74, 343–349. [Google Scholar] [CrossRef]
- Tomar, D.S.; Kumar, S.; Singh, S.K.; Goswami, S.; Li, L. Molecular basis of high viscosity in concentrated antibody solutions: Strategies for high concentration drug product development. MAbs 2016, 8, 216–228. [Google Scholar] [CrossRef]
- Wang, W.; Chen, N.; Shen, X.; Cunningham, P.; Fauty, S.; Michel, K.; Wang, B.; Hong, X.; Adreani, C.; Nunes, C.N.; et al. Lymphatic transport and catabolism of therapeutic proteins after subcutaneous administration to rats and dogs. Drug Metab. Dispos. 2012, 40, 952–962. [Google Scholar] [CrossRef]
- Hamuro, L.; Kijanka, G.; Kinderman, F.; Kropshofer, H.; Bu, D.X.; Zepeda, M.; Jawa, V. Perspectives on Subcutaneous Route of Administration as an Immunogenicity Risk Factor for Therapeutic Proteins. J. Pharm. Sci. 2017, 106, 2946–2954. [Google Scholar] [CrossRef]
- Supersaxo, A.; Hein, W.R.; Steffen, H. Effect of molecular weight on the lymphatic absorption of water-soluble compounds following subcutaneous administration. Pharm. Res. 1990, 7, 167–169. [Google Scholar] [CrossRef]
- FDA: Novel Drug Approvals for 2017. Available online: https://www.fda.gov/drugs/new-drugs-fda-cders-new-molecular-entities-and-new-therapeutic-biological-products/novel-drug-approvals-2017 (accessed on 23 August 2023).
- FDA: Novel Drug Approvals for 2018. Available online: https://www.fda.gov/drugs/new-drugs-fda-cders-new-molecular-entities-and-new-therapeutic-biological-products/novel-drug-approvals-2018 (accessed on 23 August 2023).
- FDA: Novel Drug Approvals for 2019. Available online: https://www.fda.gov/drugs/new-drugs-fda-cders-new-molecular-entities-and-new-therapeutic-biological-products/novel-drug-approvals-2019 (accessed on 23 August 2023).
- FDA: Novel Drugs Approvals for 2020. Available online: https://www.fda.gov/drugs/new-drugs-fda-cders-new-molecular-entities-and-new-therapeutic-biological-products/novel-drug-approvals-2020 (accessed on 23 August 2023).
- FDA: Novel Drug Approvals for 2021. Available online: https://www.fda.gov/drugs/new-drugs-fda-cders-new-molecular-entities-and-new-therapeutic-biological-products/novel-drug-approvals-2021 (accessed on 23 August 2023).
- FDA: Novel Drug Approvals for 2022. Available online: https://www.fda.gov/drugs/new-drugs-fda-cders-new-molecular-entities-and-new-therapeutic-biological-products/novel-drug-approvals-2022 (accessed on 23 August 2023).
- FDA: Novel Drug Approvals for 2023. Available online: https://www.fda.gov/drugs/new-drugs-fda-cders-new-molecular-entities-and-new-therapeutic-biological-products/novel-drug-approvals-2023 (accessed on 23 August 2023).
- Devadasu, V.R.; Deb, P.K.; Maheshwari, R.; Sharma, P.; Tekade, R.K. Physicochemical, Pharmaceutical, and Biological Considerations in GIT Absorption of Drugs. In Dosage Form Design Consideration; Tekade, R.K., Ed.; Academic Press: Cambridge, MA, USA, 2018; pp. 149–178. [Google Scholar]
- Han, Y.; Gao, Z.; Chen, L.; Kang, L.; Huang, W.; Jin, M.; Wang, Q.; Bae, Y.H. Multifunctional oral delivery systems for enhanced bioavailability of therapeutic peptides/proteins. Acta Pharm. Sin. B 2019, 9, 902–922. [Google Scholar] [CrossRef]
- Abuhelwa, A.Y.; Williams, D.B.; Upton, R.N.; Foster, D.J. Food, gastrointestinal pH, and models of oral drug absorption. Eur. J. Pharm. Biopharm. 2017, 112, 234–248. [Google Scholar] [CrossRef] [PubMed]
- Wright, L.; Barnes, T.J.; Prestidge, C.A. Oral delivery of protein-based therapeutics: Gastroprotective strategies, physiological barriers and in vitro permeability prediction. Int. J. Pharm. 2020, 585, 119488. [Google Scholar] [CrossRef]
- Brown, T.D.; Whitehead, K.A.; Mitragotri, S. Materials for oral delivery of proteins and peptides. Nat. Rev. Mater. 2020, 5, 127–148. [Google Scholar] [CrossRef]
- Linnankoski, J.; Mäkelä, J.; Palmgren, J.; Mauriala, T.; Vedin, C.; Ungell, A.L.; Lazorova, L.; Artursson, P.; Urtti, A.; Yliperttula, M. Paracellular porosity and pore size of the human intestinal epithelium in tissue and cell culture models. J. Pharm. Sci. 2010, 99, 2166–2175. [Google Scholar] [CrossRef]
- Zhu, Q.; Chen, Z.; Paul, P.K.; Lu, Y.; Wu, W.; Qi, J. Oral delivery of proteins and peptides: Challenges, status quo and future perspectives. Acta Pharm. Sin. B 2021, 11, 2416–2448. [Google Scholar] [CrossRef] [PubMed]
- Turner, J.R. Intestinal mucosal barrier function in health and disease. Nat. Rev. Immunol. 2009, 9, 799–809. [Google Scholar] [CrossRef] [PubMed]
- Thwala, L.N.; Préat, V.; Csaba, N.S. Emerging delivery platforms for mucosal administration of biopharmaceuticals: A critical update on nasal, pulmonary and oral routes. Expert Opin. Drug Deliv. 2017, 14, 23–36. [Google Scholar] [CrossRef]
- Anselmo, A.C.; Gokarn, Y.; Mitragotri, S. Non-invasive delivery strategies for biologics. Nat. Rev. Drug Discov. 2019, 18, 19–40. [Google Scholar] [CrossRef]
- Balcão, V.; Moutinho, C. Proteins and Peptides: Non-Invasive Delivery. In Encyclopedia of Pharmaceutical Science and Technology; Informa Healthcare: London, UK, 2013; pp. 2555–2578. [Google Scholar]
- Yoshida, H.; Usui, A.; Abe, Y.; Goda, Y.; Izutsu, K.-I. Relationship Between Geometric and Aerodynamic Particle Size Distributions in the Formulation of Solution and Suspension Metered-Dose Inhalers. AAPS PharmSciTech 2020, 21, 158. [Google Scholar] [CrossRef]
- Patton, J.S.; Brain, J.D.; Davies, L.A.; Fiegel, J.; Gumbleton, M.; Kim, K.J.; Sakagami, M.; Vanbever, R.; Ehrhardt, C. The particle has landed—Characterizing the fate of inhaled pharmaceuticals. J. Aerosol. Med. Pulm. Drug Deliv. 2010, 23, 71–87. [Google Scholar] [CrossRef]
- Matthews, A.A.; Ee, P.L.R.; Ge, R. Developing inhaled protein therapeutics for lung diseases. Mol. Biomed. 2020, 1, 11. [Google Scholar] [CrossRef] [PubMed]
- Jin, L.; Zhou, Q.T.; Chan, H.K.; Larson, I.C.; Pennington, M.W.; Morales, R.A.V.; Boyd, B.J.; Norton, R.S.; Nicolazzo, J.A. Pulmonary Delivery of the Kv1.3-Blocking Peptide HsTX1[R14A] for the Treatment of Autoimmune Diseases. J. Pharm. Sci. 2016, 105, 650–656. [Google Scholar] [CrossRef] [PubMed]
- Patton, J.S.; Fishburn, C.S.; Weers, J.G. The lungs as a portal of entry for systemic drug delivery. Proc. Am. Thorac. Soc. 2004, 1, 338–344. [Google Scholar] [CrossRef] [PubMed]
- Meng, T.; Kulkarni, V.; Simmers, R.; Brar, V.; Xu, Q. Therapeutic implications of nanomedicine for ocular drug delivery. Drug Discov. Today 2019, 24, 1524–1538. [Google Scholar] [CrossRef]
- Bachu, R.D.; Chowdhury, P.; Al-Saedi, Z.H.F.; Karla, P.K.; Boddu, S.H.S. Ocular Drug Delivery Barriers-Role of Nanocarriers in the Treatment of Anterior Segment Ocular Diseases. Pharmaceutics 2018, 10, 28. [Google Scholar] [CrossRef] [PubMed]
- Patel, A.; Cholkar, K.; Agrahari, V.; Mitra, A.K. Ocular drug delivery systems: An overview. World J. Pharmacol. 2013, 2, 47–64. [Google Scholar] [CrossRef]
- Sridhar, M.S. Anatomy of cornea and ocular surface. Indian J. Ophthalmol. 2018, 66, 190–194. [Google Scholar] [CrossRef]
- Gorantla, S.; Rapalli, V.K.; Waghule, T.; Singh, P.P.; Dubey, S.K.; Saha, R.N.; Singhvi, G. Nanocarriers for ocular drug delivery: Current status and translational opportunity. RSC Adv. 2020, 10, 27835–27855. [Google Scholar] [CrossRef] [PubMed]
- Chaulagain, B.; Jain, A.; Tiwari, A.; Verma, A.; Jain, S.K. Passive delivery of protein drugs through transdermal route. Artif. Cells Nanomed. Biotechnol. 2018, 46, 472–487. [Google Scholar] [CrossRef]
- Katikaneni, S. Transdermal delivery of biopharmaceuticals: Dream or reality? Ther. Deliv. 2015, 6, 1109–1116. [Google Scholar] [CrossRef]
- Naik, A.; Kalia, Y.N.; Guy, R.H. Transdermal drug delivery: Overcoming the skin’s barrier function. Pharm. Sci. Technol. Today 2000, 3, 318–326. [Google Scholar] [CrossRef] [PubMed]
- Morales, J.O.; Fathe, K.R.; Brunaugh, A.; Ferrati, S.; Li, S.; Montenegro-Nicolini, M.; Mousavikhamene, Z.; McConville, J.T.; Prausnitz, M.R.; Smyth, H.D.C. Challenges and Future Prospects for the Delivery of Biologics: Oral Mucosal, Pulmonary, and Transdermal Routes. AAPS J. 2017, 19, 652–668. [Google Scholar] [CrossRef]
- Yang, Y.; Zhou, R.; Wang, Y.; Zhang, Y.; Yu, J.; Gu, Z. Recent Advances in Oral and Transdermal Protein Delivery Systems. Angew. Chem. Int. Ed. Engl. 2023, 62, e202214795. [Google Scholar] [CrossRef]
- Koussoroplis, S.-J.; Vanbever, R. Peptides and proteins: Pulmonary absorption. In Encyclopedia of Pharmaceutical Science and Technology, 4th ed.; Taylor and Francis: Oxford, UK, 2013; pp. 2607–2618. [Google Scholar]
- Mandal, A.; Pal, D.; Agrahari, V.; Trinh, H.M.; Joseph, M.; Mitra, A.K. Ocular delivery of proteins and peptides: Challenges and novel formulation approaches. Adv. Drug Deliv. Rev. 2018, 126, 67–95. [Google Scholar] [CrossRef] [PubMed]
- FDA: FDA Approves First Drug for Neurotrophic Keratitis, a Rare Eye Disease. Available online: https://www.fda.gov/news-events/press-announcements/fda-approves-first-drug-neurotrophic-keratitis-rare-eye-disease (accessed on 23 August 2023).
- Selam, J.L. Evolution of diabetes insulin delivery devices. J. Diabetes Sci. Technol. 2010, 4, 505–513. [Google Scholar] [CrossRef]
- Wells, C.M.; Harris, M.; Choi, L.; Murali, V.P.; Guerra, F.D.; Jennings, J.A. Stimuli-Responsive Drug Release from Smart Polymers. J. Funct. Biomater. 2019, 10, 34. [Google Scholar] [CrossRef] [PubMed]
- Raza, F.; Zafar, H.; Zhu, Y.; Ren, Y.; Ullah, A.; Khan, A.U.; He, X.; Han, H.; Aquib, M.; Boakye-Yiadom, K.O.; et al. A Review on Recent Advances in Stabilizing Peptides/Proteins upon Fabrication in Hydrogels from Biodegradable Polymers. Pharmaceutics 2018, 10, 16. [Google Scholar] [CrossRef]
- Pérez-Luna, V.H.; González-Reynoso, O. Encapsulation of Biological Agents in Hydrogels for Therapeutic Applications. Gels 2018, 4, 61. [Google Scholar] [CrossRef]
- Shymborska, Y.; Budkowski, A.; Raczkowska, J.; Donchak, V.; Melnyk, Y.; Vasiichuk, V.; Stetsyshyn, Y. Switching it Up: The Promise of Stimuli-Responsive Polymer Systems in Biomedical Science. Chem. Rec. 2023, e202300217. [Google Scholar] [CrossRef] [PubMed]
- Mahlumba, P.; Choonara, Y.E.; Kumar, P.; du Toit, L.C.; Pillay, V. Stimuli-Responsive Polymeric Systems for Controlled Protein and Peptide Delivery: Future Implications for Ocular Delivery. Molecules 2016, 21, 1002. [Google Scholar] [CrossRef] [PubMed]
- Chatterjee, S.; Chi-Leung Hui, P. Review of Stimuli-Responsive Polymers in Drug Delivery and Textile Application. Molecules 2019, 24, 2547. [Google Scholar] [CrossRef]
- Jocic, D.; Tourrette, A.; Lavric, P.K. Biopolymer-based Stimuli-Responsive Polymeric Systems for Functional Finishing of Textiles. In Biopolymers; Elnashar, M., Ed.; IntechOpen: Rijeka, Croatia, 2010; Chapter 3. [Google Scholar]
- Marques, A.C.; Costa, P.J.; Velho, S.; Amaral, M.H. Stimuli-responsive hydrogels for intratumoral drug delivery. Drug Discov. Today 2021, 26, 2397–2405. [Google Scholar] [CrossRef]
- Hatakeyama, H. Recent Advances in Endogenous and Exogenous Stimuli-Responsive Nanocarriers for Drug Delivery and Therapeutics. Chem. Pharm. Bull. 2017, 65, 612–617. [Google Scholar] [CrossRef] [PubMed]
- Sarwan, T.; Kumar, P.; Choonara, Y.E.; Pillay, V. Hybrid Thermo-Responsive Polymer Systems and Their Biomedical Applications. Front. Mater. 2020, 7, 73. [Google Scholar] [CrossRef]
- Matanović, M.R.; Kristl, J.; Grabnar, P.A. Thermoresponsive polymers: Insights into decisive hydrogel characteristics, mechanisms of gelation, and promising biomedical applications. Int. J. Pharm. 2014, 472, 262–275. [Google Scholar] [CrossRef]
- Marques, A.C.; Costa, P.C.; Velho, S.; Amaral, M.H. Injectable Poloxamer Hydrogels for Local Cancer Therapy. Gels 2023, 9, 593. [Google Scholar] [CrossRef]
- Chatterjee, S.; Hui, P.C. Review of Applications and Future Prospects of Stimuli-Responsive Hydrogel Based on Thermo-Responsive Biopolymers in Drug Delivery Systems. Polymers 2021, 13, 86. [Google Scholar] [CrossRef]
- Honey Priya, J.; Rijo, J.; Anju, A.; Anoop, K.R. Smart polymers for the controlled delivery of drugs—A concise overview. Acta Pharm. Sin. B 2014, 4, 120–127. [Google Scholar] [CrossRef] [PubMed]
- Oak, M.; Mandke, R.; Singh, J. Smart polymers for peptide and protein parenteral sustained delivery. Drug Discov. Today Technol. 2012, 9, e131–e140. [Google Scholar] [CrossRef] [PubMed]
- Altomare, L.; Bonetti, L.; Campiglio, C.E.; De Nardo, L.; Draghi, L.; Tana, F.; Farè, S. Biopolymer-based strategies in the design of smart medical devices and artificial organs. Int. J. Artif. Organs 2018, 41, 337–359. [Google Scholar] [CrossRef]
- Zhang, J.; Jiang, X.; Xiang, W.; Xu, Q.; Zeng, H.; Zhao, Y.; Liu, M.; Wang, Z.; Hu, X.; Wang, Y. Bio-responsive smart polymers and biomedical applications. J. Phys. Mater. 2019, 2, 032004. [Google Scholar] [CrossRef]
- Zha, L.; Banik, B.; Alexis, F. Stimulus responsive nanogels for drug delivery. Soft Matter 2011, 7, 5908–5916. [Google Scholar] [CrossRef]
- Andrade, F.; Roca-Melendres, M.M.; Durán-Lara, E.F.; Rafael, D.; Schwartz, S., Jr. Stimuli-Responsive Hydrogels for Cancer Treatment: The Role of pH, Light, Ionic Strength and Magnetic Field. Cancers 2021, 13, 1164. [Google Scholar] [CrossRef] [PubMed]
- Rizwan, M.; Yahya, R.; Hassan, A.; Yar, M.; Azzahari, A.D.; Selvanathan, V.; Sonsudin, F.; Abouloula, C.N. pH Sensitive Hydrogels in Drug Delivery: Brief History, Properties, Swelling, and Release Mechanism, Material Selection and Applications. Polymers 2017, 9, 137. [Google Scholar] [CrossRef]
- Yoshida, T.; Lai, T.C.; Kwon, G.S.; Sako, K. pH- and ion-sensitive polymers for drug delivery. Expert Opin. Drug Deliv. 2013, 10, 1497–1513. [Google Scholar] [CrossRef]
- Lynch, C.R.; Kondiah, P.P.D.; Choonara, Y.E.; du Toit, L.C.; Ally, N.; Pillay, V. Hydrogel Biomaterials for Application in Ocular Drug Delivery. Front. Bioeng. Biotechnol. 2020, 8, 228. [Google Scholar] [CrossRef] [PubMed]
- Ferreira, N.N.; Ferreira, L.M.B.; Cardoso, V.M.O.; Boni, F.I.; Souza, A.L.R.; Gremião, M.P.D. Recent advances in smart hydrogels for biomedical applications: From self-assembly to functional approaches. Eur. Polym. J. 2018, 99, 117–133. [Google Scholar] [CrossRef]
- El-Husseiny, H.M.; Mady, E.A.; El-Dakroury, W.A.; Doghish, A.S.; Tanaka, R. Stimuli-responsive hydrogels: Smart state of-the-art platforms for cardiac tissue engineering. Front. Bioeng. Biotechnol. 2023, 11, 1174075. [Google Scholar] [CrossRef]
- Feng, Y.; Taraban, M.; Yu, Y.B. The Effect of Ionic Strength on the Mechanical, Structural and Transport Properties of Peptide Hydrogels. Soft Matter 2012, 8, 11723–11731. [Google Scholar] [CrossRef] [PubMed]
- Rudko, M.; Urbaniak, T.; Musiał, W. Recent Developments in Ion-Sensitive Systems for Pharmaceutical Applications. Polymers 2021, 13, 1641. [Google Scholar] [CrossRef]
- Omtvedt, L.A.; Kristiansen, K.A.; Strand, W.I.; Aachmann, F.L.; Strand, B.L.; Zaytseva-Zotova, D.S. Alginate hydrogels functionalized with β-cyclodextrin as a local paclitaxel delivery system. J. Biomed. Mater. Res. A 2021, 109, 2625–2639. [Google Scholar] [CrossRef]
- Zhang, H.; Cheng, J.; Ao, Q. Preparation of Alginate-Based Biomaterials and Their Applications in Biomedicine. Mar. Drugs 2021, 19, 264. [Google Scholar] [CrossRef]
- Sharifzadeh, G.; Hosseinkhani, H. Biomolecule-Responsive Hydrogels in Medicine. Adv. Healthc. Mater. 2017, 6, 1700801. [Google Scholar] [CrossRef] [PubMed]
- Cao, J.; Yuan, P.; Wu, B.; Liu, Y.; Hu, C. Advances in the Research and Application of Smart-Responsive Hydrogels in Disease Treatment. Gels 2023, 9, 662. [Google Scholar] [CrossRef] [PubMed]
- Zhao, L.; Wang, L.; Zhang, Y.; Xiao, S.; Bi, F.; Zhao, J.; Gai, G.; Ding, J. Glucose Oxidase-Based Glucose-Sensitive Drug Delivery for Diabetes Treatment. Polymers 2017, 9, 255. [Google Scholar] [CrossRef]
- Mantha, S.; Pillai, S.; Khayambashi, P.; Upadhyay, A.; Zhang, Y.; Tao, O.; Pham, H.M.; Tran, S.D. Smart Hydrogels in Tissue Engineering and Regenerative Medicine. Materials 2019, 12, 3323. [Google Scholar] [CrossRef]
- Ma, Q.; Zhao, X.; Shi, A.; Wu, J. Bioresponsive Functional Phenylboronic Acid-Based Delivery System as an Emerging Platform for Diabetic Therapy. Int. J. Nanomed. 2021, 16, 297–314. [Google Scholar] [CrossRef]
- Morariu, S. Advances in the Design of Phenylboronic Acid-Based Glucose-Sensitive Hydrogels. Polymers 2023, 15, 582. [Google Scholar] [CrossRef] [PubMed]
- Lim, S.L.; Ooi, C.-W.; Low, L.E.; Tan, W.S.; Chan, E.-S.; Ho, K.L.; Tey, B.T. Synthesis of poly(acrylamide)-based hydrogel for bio-sensing of hepatitis B core antigen. Mater. Chem. Phys. 2020, 243, 122578. [Google Scholar] [CrossRef]
- Li, X.; Duan, L.; Kong, M.; Wen, X.; Guan, F.; Ma, S. Applications and Mechanisms of Stimuli-Responsive Hydrogels in Traumatic Brain Injury. Gels 2022, 8, 482. [Google Scholar] [CrossRef]
- Qiu, Y.; Park, K. Environment-sensitive hydrogels for drug delivery. Adv. Drug Deliv. Rev. 2001, 53, 321–339. [Google Scholar] [CrossRef]
- Di, Y.; Wang, P.; Li, C.; Xu, S.; Tian, Q.; Wu, T.; Tian, Y.; Gao, L. Design, Bioanalytical, and Biomedical Applications of Aptamer-Based Hydrogels. Front. Med. 2020, 7, 456. [Google Scholar] [CrossRef] [PubMed]
- Chang, D.; Ma, Y.; Xu, X.; Xie, J.; Ju, S. Stimuli-Responsive Polymeric Nanoplatforms for Cancer Therapy. Front. Bioeng. Biotechnol. 2021, 9, 707319. [Google Scholar] [CrossRef]
- Zhao, Y.; Ran, B.; Xie, X.; Gu, W.; Ye, X.; Liao, J. Developments on the Smart Hydrogel-Based Drug Delivery System for Oral Tumor Therapy. Gels 2022, 8, 741. [Google Scholar] [CrossRef]
- Chandrawati, R. Enzyme-responsive polymer hydrogels for therapeutic delivery. Exp. Biol. Med. 2016, 241, 972–979. [Google Scholar] [CrossRef]
- Zelzer, M.; Todd, S.J.; Hirst, A.R.; McDonald, T.O.; Ulijn, R.V. Enzyme responsive materials: Design strategies and future developments. Biomater. Sci. 2013, 1, 11–39. [Google Scholar] [CrossRef]
- Bonacucina, G.; Cespi, M.; Mencarelli, G.; Giorgioni, G.; Palmieri, G.F. Thermosensitive Self-Assembling Block Copolymers as Drug Delivery Systems. Polymers 2011, 3, 779–811. [Google Scholar] [CrossRef]
- Pita-Vilar, M.; Concheiro, A.; Alvarez-Lorenzo, C.; Diaz-Gomez, L. Recent advances in 3D printed cellulose-based wound dressings: A review on in vitro and in vivo achievements. Carbohydr. Polym. 2023, 321, 121298. [Google Scholar] [CrossRef]
- EFSA Panel on Food Additives and Nutrient Sources Added to Food (ANS); Younes, M.; Aggett, P.; Aguilar, F.; Crebelli, R.; Dusemund, B.; Filipič, M.; Frutos, M.J.; Galtier, P.; Gundert-Remy, U.; et al. Safety of low-substituted hydroxypropyl cellulose (L-HPC) to be used as a food additive in food supplements in tablet form. EFSA J. 2018, 16, e05062. [Google Scholar] [CrossRef]
- Piqué, N.; Gómez-Guillén, M.D.C.; Montero, M.P. Xyloglucan, a Plant Polymer with Barrier Protective Properties over the Mucous Membranes: An Overview. Int. J. Mol. Sci. 2018, 19, 673. [Google Scholar] [CrossRef] [PubMed]
- Burdock, G.A. Safety assessment of hydroxypropyl methylcellulose as a food ingredient. Food Chem. Toxicol. 2007, 45, 2341–2351. [Google Scholar] [CrossRef] [PubMed]
- Yang, L.; Fan, X.; Zhang, J.; Ju, J. Preparation and Characterization of Thermoresponsive Poly(N-Isopropylacrylamide) for Cell Culture Applications. Polymers 2020, 12, 389. [Google Scholar] [CrossRef]
- Iglesias, N.; Galbis, E.; Romero-Azogil, L.; Benito, E.; Lucas, R.; García-Martín, M.G.; de-Paz, M.V. In-Depth Study into Polymeric Materials in Low-Density Gastroretentive Formulations. Pharmaceutics 2020, 12, 636. [Google Scholar] [CrossRef] [PubMed]
- Mathaba, M.; Daramola, M.O. Effect of Chitosan’s Degree of Deacetylation on the Performance of PES Membrane Infused with Chitosan during AMD Treatment. Membranes 2020, 10, 52. [Google Scholar] [CrossRef]
- Olaru, N.; Olaru, L. Phthaloylation of cellulose acetate in acetic acid and acetone Media. Iran. Polym. J. 2005, 14, 1058–1065. [Google Scholar]
- Manouchehri, S.; Zarrintaj, P.; Saeb, M.R.; Ramsey, J.D. Advanced Delivery Systems Based on Lysine or Lysine Polymers. Mol. Pharm. 2021, 18, 3652–3670. [Google Scholar] [CrossRef]
- Okayasu, T.; Hibino, T.; Nishide, H. Free Radical Polymerization Kinetics of Vinylsulfonic Acid and Highly Acidic Properties of its Polymer. Macromol. Chem. Phys. 2011, 212, 1072–1079. [Google Scholar] [CrossRef]
- Holmes, P.F.; Bohrer, M.; Kohn, J. Exploration of polymethacrylate structure-property correlations: Advances towards combinatorial and high-throughput methods for biomaterials discovery. Prog. Polym. Sci. 2008, 33, 787–796. [Google Scholar] [CrossRef] [PubMed]
- Osmałek, T.; Froelich, A.; Tasarek, S. Application of gellan gum in pharmacy and medicine. Int. J. Pharm. 2014, 466, 328–340. [Google Scholar] [CrossRef]
- Jadav, M.; Pooja, D.; Adams, D.J.; Kulhari, H. Advances in Xanthan Gum-Based Systems for the Delivery of Therapeutic Agents. Pharmaceutics 2023, 15, 402. [Google Scholar] [CrossRef]
- Torres, M.D.; Flórez-Fernández, N.; Domínguez, H. Integral Utilization of Red Seaweed for Bioactive Production. Mar. Drugs 2019, 17, 314. [Google Scholar] [CrossRef] [PubMed]
- Chandel, V.; Biswas, D.; Roy, S.; Vaidya, D.; Verma, A.; Gupta, A. Current Advancements in Pectin: Extraction, Properties and Multifunctional Applications. Foods 2022, 11, 2683. [Google Scholar] [CrossRef]
- Liu, L.; Liu, Y.; Li, J.; Du, G.; Chen, J. Microbial production of hyaluronic acid: Current state, challenges, and perspectives. Microb. Cell Fact. 2011, 10, 99. [Google Scholar] [CrossRef] [PubMed]
- Yáñez-Fernández, J.; Herrera Ovando, M.G.; Patlán Ramírez, L.; Ramírez-Sotelo, G.; Guarin, C.A.; Castro-Rodríguez, D.C. Factorial Design to Optimize Dextran Production by the Native Strain Leuconostoc mesenteroides SF3. ACS Omega 2021, 6, 31203–31210. [Google Scholar] [CrossRef] [PubMed]
- Vojkovsky, T.; Sullivan, B.; Sill, K.N. Synthesis of heterobifunctional polyethylene glycols: Polymerization from functional initiators. Polymer 2016, 105, 72–78. [Google Scholar] [CrossRef]
- Jurko, L.; Bračič, M.; Hribernik, S.; Makuc, D.; Plavec, J.; Jerenec, F.; Žabkar, S.; Gubeljak, N.; Štern, A.; Kargl, R. Succinylation of Polyallylamine: Influence on Biological Efficacy and the Formation of Electrospun Fibers. Polymers 2021, 13, 2840. [Google Scholar] [CrossRef]
- Municoy, S.; Álvarez Echazú, M.I.; Antezana, P.E.; Galdopórpora, J.M.; Olivetti, C.; Mebert, A.M.; Foglia, M.L.; Tuttolomondo, M.V.; Alvarez, G.S.; Hardy, J.G.; et al. Stimuli-Responsive Materials for Tissue Engineering and Drug Delivery. Int. J. Mol. Sci. 2020, 21, 4724. [Google Scholar] [CrossRef]
- Fu, X.; Hosta-Rigau, L.; Chandrawati, R.; Cui, J. Multi-Stimuli-Responsive Polymer Particles, Films, and Hydrogels for Drug Delivery. Chem 2018, 4, 2084–2107. [Google Scholar] [CrossRef]
- Cheng, R.; Meng, F.; Deng, C.; Klok, H.A.; Zhong, Z. Dual and multi-stimuli responsive polymeric nanoparticles for programmed site-specific drug delivery. Biomaterials 2013, 34, 3647–3657. [Google Scholar] [CrossRef] [PubMed]
- Pham, S.H.; Choi, Y.; Choi, J. Stimuli-Responsive Nanomaterials for Application in Antitumor Therapy and Drug Delivery. Pharmaceutics 2020, 12, 630. [Google Scholar] [CrossRef]
- Lima, D.S.; Tenório-Neto, E.T.; Lima-Tenório, M.K.; Guilherme, M.R.; Scariot, D.B.; Nakamura, C.V.; Muniz, E.C.; Rubira, A.F. pH-responsive alginate-based hydrogels for protein delivery. J. Mol. Liq. 2018, 262, 29–36. [Google Scholar] [CrossRef]
- Phan, V.H.G.; Thambi, T.; Gil, M.S.; Lee, D.S. Temperature and pH-sensitive injectable hydrogels based on poly(sulfamethazine carbonate urethane) for sustained delivery of cationic proteins. Polymer 2017, 109, 38–48. [Google Scholar] [CrossRef]
- Sarkar, S.; Gulati, K.; Mishra, A.; Poluri, K.M. Protein nanocomposites: Special inferences to lysozyme based nanomaterials. Int. J. Biol. Macromol. 2020, 151, 467–482. [Google Scholar] [CrossRef]
- Xu, H.L.; Xu, J.; Zhang, S.S.; Zhu, Q.Y.; Jin, B.H.; ZhuGe, D.L.; Shen, B.X.; Wu, X.Q.; Xiao, J.; Zhao, Y.Z. Temperature-sensitive heparin-modified poloxamer hydrogel with affinity to KGF facilitate the morphologic and functional recovery of the injured rat uterus. Drug Deliv. 2017, 24, 867–881. [Google Scholar] [CrossRef] [PubMed]
- Dutta, K.; Das, R.; Ling, J.; Monibas, R.M.; Carballo-Jane, E.; Kekec, A.; Feng, D.D.; Lin, S.; Mu, J.; Saklatvala, R.; et al. In Situ Forming Injectable Thermoresponsive Hydrogels for Controlled Delivery of Biomacromolecules. ACS Omega 2020, 5, 17531–17542. [Google Scholar] [CrossRef]
- Hu, D.-N.; Ju, X.-J.; Pu, X.-Q.; Xie, R.; Wang, W.; Liu, Z.; Chu, L.-Y. Injectable Temperature/Glucose Dual-Responsive Hydrogels for Controlled Release of Insulin. Ind. Eng. Chem. Res. 2021, 60, 8147–8158. [Google Scholar] [CrossRef]
- Rahmanian, E.; Salari, N.; Mohammadi, M.; Jalali, R. Evaluation of sexual dysfunction and female sexual dysfunction indicators in women with type 2 diabetes: A systematic review and meta-analysis. Diabetol. Metab. Syndr. 2019, 11, 73. [Google Scholar] [CrossRef]
- Tong, M.Q.; Luo, L.Z.; Xue, P.P.; Han, Y.H.; Wang, L.F.; Zhuge, D.L.; Yao, Q.; Chen, B.; Zhao, Y.Z.; Xu, H.L. Glucose-responsive hydrogel enhances the preventive effect of insulin and liraglutide on diabetic nephropathy of rats. Acta Biomater. 2021, 122, 111–132. [Google Scholar] [CrossRef] [PubMed]
- Lu, L.; Zou, Y.; Yang, W.; Meng, F.; Deng, C.; Cheng, R.; Zhong, Z. Anisamide-Decorated pH-Sensitive Degradable Chimaeric Polymersomes Mediate Potent and Targeted Protein Delivery to Lung Cancer Cells. Biomacromolecules 2015, 16, 1726–1735. [Google Scholar] [CrossRef] [PubMed]
- Rousalova, I.; Krepela, E. Granzyme B-induced apoptosis in cancer cells and its regulation (review). Int. J. Oncol. 2010, 37, 1361–1378. [Google Scholar] [CrossRef] [PubMed]
- Pang, X.; Liang, S.; Wang, T.; Yu, S.; Yang, R.; Hou, T.; Liu, Y.; He, C.; Zhang, N. Engineering Thermo-pH Dual Responsive Hydrogel for Enhanced Tumor Accumulation, Penetration, and Chemo-Protein Combination Therapy. Int. J. Nanomed. 2020, 15, 4739–4752. [Google Scholar] [CrossRef] [PubMed]
- Lazzaro, B.P.; Zasloff, M.; Rolff, J. Antimicrobial peptides: Application informed by evolution. Science 2020, 368, eaau5480. [Google Scholar] [CrossRef]
- Mahlapuu, M.; Håkansson, J.; Ringstad, L.; Björn, C. Antimicrobial Peptides: An Emerging Category of Therapeutic Agents. Front. Cell Infect. Microbiol. 2016, 6, 194. [Google Scholar] [CrossRef]
- Rezaei, N.; Hamidabadi, H.G.; Khosravimelal, S.; Zahiri, M.; Ahovan, Z.A.; Bojnordi, M.N.; Eftekhari, B.S.; Hashemi, A.; Ganji, F.; Darabi, S.; et al. Antimicrobial peptides-loaded smart chitosan hydrogel: Release behavior and antibacterial potential against antibiotic resistant clinical isolates. Int. J. Biol. Macromol. 2020, 164, 855–862. [Google Scholar] [CrossRef]
- Nie, L.; Chang, P.; Sun, M.; Huo, H.; Zhang, C.; Ji, C.; Wei, X.; Zhou, Q.; Guo, P.; Yuan, H. Composite Hydrogels with the Simultaneous Release of VEGF and MCP-1 for Enhancing Angiogenesis for Bone Tissue Engineering Applications. Appl. Sci. 2018, 8, 2438. [Google Scholar] [CrossRef]
- Liu, L.; Zhang, Y.; Yu, S.; Yang, Z.; He, C.; Chen, X. Dual Stimuli-Responsive Nanoparticle-Incorporated Hydrogels as an Oral Insulin Carrier for Intestine-Targeted Delivery and Enhanced Paracellular Permeation. ACS Biomater. Sci. Eng. 2018, 4, 2889–2902. [Google Scholar] [CrossRef]
- Bao, X.; Si, X.; Ding, X.; Duan, L.; Xiao, C. pH-responsive hydrogels based on the self-assembly of short polypeptides for controlled release of peptide and protein drugs. J. Polym. Res. 2019, 26, 278. [Google Scholar] [CrossRef]
- Li, X.; Fu, M.; Wu, J.; Zhang, C.; Deng, X.; Dhinakar, A.; Huang, W.; Qian, H.; Ge, L. pH-sensitive peptide hydrogel for glucose-responsive insulin delivery. Acta Biomater. 2017, 51, 294–303. [Google Scholar] [CrossRef]
- Gohil, S.V.; Padmanabhan, A.; Kan, H.M.; Khanal, M.; Nair, L.S. Degradation-Dependent Protein Release from Enzyme Sensitive Injectable Glycol Chitosan Hydrogel. Tissue Eng. Part A 2021, 27, 867–880. [Google Scholar] [CrossRef] [PubMed]
- Fox, M.E.; Szoka, F.C.; Fréchet, J.M.J. Soluble Polymer Carriers for the Treatment of Cancer: The Importance of Molecular Architecture. Acc. Chem. Res. 2009, 42, 1141–1151. [Google Scholar] [CrossRef] [PubMed]
- Nastyshyn, S.; Pop-Georgievski, O.; Stetsyshyn, Y.; Budkowski, A.; Raczkowska, J.; Hruby, M.; Lobaz, V. Protein corona of SiO2 nanoparticles with grafted thermoresponsive copolymers: Calorimetric insights on factors affecting entropy vs. enthalpy-driven associations. Appl. Surf. Sci. 2022, 601, 154201. [Google Scholar] [CrossRef]

| Year | Active Ingredient Trade Name | Description | Pharmaceutical Dosage Form | Indication |
|---|---|---|---|---|
| 2017 | Etelcalcetide Parsabiv® | Calcium-sensing receptor agonist | Injectable solution (IV) | Hyperparathyroidism |
| 2017 | Semaglutide Ozempic® | Glucagon-like peptide 1 (GLP-1) receptor agonist | Injectable solution (SC) | Diabetes |
| 2018 | Tildrakizumab Ilumya® | Interleukin-23 antagonist | Injectable solution (SC) | Moderate-to-severe plaque psoriasis |
| 2018 | Cemiplimab Libtayo® | Programmed death receptor-1 (PD-1) blocking antibody | Injectable solution (IV) | Cutaneous squamous-cell carcinoma |
| 2018 | Calaspargase pegol Asparlas® | Asparagine-specific enzyme | Injectable solution (IV) | Acute lymphoblastic leukemia |
| 2019 | Crizanlizumab-tmca Adakveo® | Selectin-blocking antibody | Injectable solution (IV) | Pain caused by sickle cell disease |
| 2020 | Setmelanotide ImcivreeTM | Melanocortin 4 (MC4) receptor agonist | Injectable solution (SC) | Chronic weight management |
| 2020 | Somapacitan-beco Sogroya® | Human growth hormone analog | Injectable solution (SC) | Growth hormone deficiency |
| 2020 | Ansuvimab-zykl EbangaTM | Zaire ebolavirus glycoprotein (EBOV GP)-directed human monoclonal antibody | Injectable solution (IV) | Infection caused by Zaire ebolavirus |
| 2021 | Dasiglucagon Zegalogue® | Anti-hypoglycemic agent | Injectable solution (SC) | Severe hypoglycemia |
| 2021 | Dostarlimab-gxly Jemperli® | Programmed death receptor-1 (PD-1) blocking antibody | Injectable solution (IV) | Endometrial cancer |
| 2022 | Olipudase alfa XenpozymeTM | Sphingomyelin-specific enzyme | Injectable solution (IV) | Acid sphingomyelinase deficiency |
| 2023 | Pegunigalsidase alfa-iwxj Elfabrio® | Glycosphingolipid-specific enzyme | Injectable solution (IV) | Fabry disease |
| 2023 | Somatrogon-ghla NgenlaTM | Human growth hormone analog | Injectable solution (SC) | Growth hormone deficiency |
| 2023 | Pozelimab-bbfg VeopozTM | Recombinant IgG4 monoclonal antibody | Injectable solution (IV or SC) | CHAPLE disease |
| Route | Protein or Peptide | Trade Name | Company | Indication | Ref. |
|---|---|---|---|---|---|
| Oral | Cyclosporin A | Neoral® | Novartis (Switzerland) | Systemic immunosuppressive therapy | [50,53] |
| Pancrelipase | Creon® | AbbVie (USA) | Exocrine pancreatic insufficiency | ||
| Linaclotide | Linzess® | Actavis (USA) | Irritable bowel syndrome and chronic idiopathic constipation | ||
| Tilactase | Lacteeze® | Lacteeze (USA) | Lactose intolerance | ||
| Vancomycin | Vancocin® | ANI Pharmaceuticals (USA) | Infection | ||
| Octreotide | Mycapssa® | Chiasma (USA) | Long-term maintenance treatment in acromegaly patients | ||
| Semaglutide | Rybelsus® | Novo Nordisk (Denmark) | Type 2 diabetes mellitus | ||
| Nasal | Desmopressin | DDAVP® | Ferring Pharmaceuticals (Switzerland) | Antidiuretic replacement therapy in the management of central diabetes insipidus | [1,56] |
| Calcitonin | Miacalcin® | Novartis (Switzerland) | Postmenopausal osteoporosis | ||
| Fortical® | Upsher-Smith (USA) | Hypercalcemia, osteoporosis | |||
| Oxytocin | Syntocinon® | Novartis (Switzerland) | Induction of labor | ||
| Nafarelin | Synarel® | Pfizer (USA) | Central precocious puberty | ||
| Buserelin | Suprecur® | Sanofi-Aventis (FR) | Prostate cancer, endometriosis | ||
| Pulmonary | Dornase alfa | Pulmozyme® | Genentech (USA) | Cystic fibrosis | [56,73] |
| Insulin | Afrezza® | MannKind (USA) | Diabetes mellitus | ||
| Ocular | Ranibizumab | Lucentis® | Genentech (USA) | Neovascular age-related macular degeneration; diabetic retinopathy | [74,75] |
| Pegaptanib sodium | Macugen® | Eyetech Pharmaceuticals and Pfizer (USA) | Neovascular age-related macular degeneration | ||
| Aflibercept | Eylea® | Regeneron Pharmaceuticals (USA) | Neovascular age-related macular degeneration; diabetic retinopathy | ||
| Cenegermin | Oxervate™ | Dompé (IT) | Neurotrophic keratitis treatment | ||
| Transdermal | Insulin | Solo™ | Medingo (USA) | Diabetes mellitus | [76] |
| Stimuli | Polymers | Origin/Synthesis | Ref. |
|---|---|---|---|
| Temperature | Poloxamers | Sequential polymerization of propylene oxide and ethylene oxide in the presence of alkaline catalysts | [119] |
| Methyl cellulose | Reaction of alkali cellulose with methylene chloride | [120] | |
| Hydroxypropylcellulose | Reaction of alkali cellulose with propylene oxide | [121] | |
| Xyloglucan | Extraction from the seed of the tamarind tree (Tamarindus indica) | [122] | |
| Hydroxypropylmethylcellulose | Reaction of alkali cellulose with methylene chloride and propylene oxide | [123] | |
| Poly(N-isopropylacrylamide) | Free-radical polymerization of N-isopropylacrylamide | [124] | |
| pH | Carbomers | Crosslinking of polyacrylic acids with the allyl ethers of pentaerythritol or sucrose | [125] |
| Chitosan | Partial N-deacetylation of chitin | [126] | |
| Cellulose acetate phthalate | Reaction of a partially substituted cellulose acetate with phthalic anhydride in the presence of an organic solvent and a basic catalyst | [127] | |
| Sodium carboxymethyl cellulose | Reaction of alkali cellulose with sodium monochloroacetate | [120] | |
| Poly(L-lysine) | Biosynthesis by the bacterium strain Streptomyces albulus | [128] | |
| Polyvinyl sulfonic acid | Free-radical polymerization of vinyl sulfonic acid | [129] | |
| Polymethacrylic acid | Free-radical polymerization of methacrylic acid | [130] | |
| Ionic strength | Gellan gum | Biosynthesis by Sphingomonas elodea | [131] |
| Alginates | Extraction from brown marine algae and Pseudomonas and Azotobacter bacteria | [104] | |
| Xanthan gum | Biosynthesis by Xanthomonas campestris | [132] | |
| Carrageenan | Extraction from red seaweeds (Rhodophyta) | [133] | |
| Pectin | Extraction from citrus and apple fruits | [134] | |
| Hyaluronic acid | Biosynthesis by Streptococcus zooepidemicus and recombinant systems | [135] | |
| Enzyme | Dextran | Biosynthesis by Leuconostoc mesenteroides NRRL B-512F | [136] |
| Hyaluronic acid | Biosynthesis by Streptococcus zooepidemicus and recombinant systems | [135] | |
| Polyethylene glycol | Ring-opening polymerization of ethylene oxide | [137] | |
| Poly(allylamine) | Polymerization of allylamine | [138] |
| Proteins | Stimuli Responsiveness Composition | Route | Highlights | Ref. |
|---|---|---|---|---|
| Vascular endothelial growth factor and monocyte chemotactic protein-1 | Temperature-responsive PLGA-mPEG | Intrafemoral |
| [157] |
| Insulin | pH- and amylase-responsive CMS-g-AA/PMAA | Oral |
| [158] |
| BSA and insulin | pH-responsive 4a-PEG-PLG | Oral or SC |
| [159] |
| Insulin | Glucose- and pH-responsive PBA, glucose oxidase and catalase | SC |
| [160] |
| FITC-BSA | Enzyme-responsive HPP-GC | SC |
| [161] |
Disclaimer/Publisher’s Note: The statements, opinions and data contained in all publications are solely those of the individual author(s) and contributor(s) and not of MDPI and/or the editor(s). MDPI and/or the editor(s) disclaim responsibility for any injury to people or property resulting from any ideas, methods, instructions or products referred to in the content. |
© 2023 by the authors. Licensee MDPI, Basel, Switzerland. This article is an open access article distributed under the terms and conditions of the Creative Commons Attribution (CC BY) license (https://creativecommons.org/licenses/by/4.0/).
Share and Cite
Malta, R.; Marques, A.C.; Costa, P.C.d.; Amaral, M.H. Stimuli-Responsive Hydrogels for Protein Delivery. Gels 2023, 9, 802. https://doi.org/10.3390/gels9100802
Malta R, Marques AC, Costa PCd, Amaral MH. Stimuli-Responsive Hydrogels for Protein Delivery. Gels. 2023; 9(10):802. https://doi.org/10.3390/gels9100802
Chicago/Turabian StyleMalta, Rafaela, Ana Camila Marques, Paulo Cardoso da Costa, and Maria Helena Amaral. 2023. "Stimuli-Responsive Hydrogels for Protein Delivery" Gels 9, no. 10: 802. https://doi.org/10.3390/gels9100802
APA StyleMalta, R., Marques, A. C., Costa, P. C. d., & Amaral, M. H. (2023). Stimuli-Responsive Hydrogels for Protein Delivery. Gels, 9(10), 802. https://doi.org/10.3390/gels9100802

